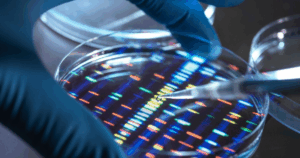
Японські вчені застосували CRISPR для видалення зайвої хромосоми при синдромі Дауна

Японські вчені застосували CRISPR для видалення зайвої хромосоми при синдромі Дауна
Японські дослідники розробили новий підхід до лікування синдрому Дауна за допомогою редагування генів CRISPR-Cas9. Це захворювання виникає внаслідок наявності додаткової копії 21-ї хромосоми. Вчені з Університету Мі представили результати своєї роботи у виданні PNAS Nexus.
Дослідження вчених з Університету Мі опубліковане у виданні PNAS Nexus.
«Ми налаштували систему CRISPR так, щоб вона прицільно впливала лише на зайву хромосому, не пошкоджуючи нормальну пару. Головна мета полягала в тому, щоб усунути надлишковий генетичний матеріал і відновити нормальну експресію генів у клітинах», — пояснив керівник дослідження Рьотаро Хашизуме.
Досліди проводили як на стовбурових клітинах, вирощених у лабораторії, так і на фібробластах шкіри, отриманих у людей із синдромом Дауна. Після усунення додаткової хромосоми науковці зафіксували нормалізацію експресії генів та синтезу білків.
За словами дослідників, корекція хромосомних аномалій була помітна навіть у зрілих клітинах, що відкриває перспективи для терапії різних типів тканин. Крім того, виправлені клітини демонстрували швидший ріст і коротший час подвоєння порівняно з необробленими трисомними клітинами.







